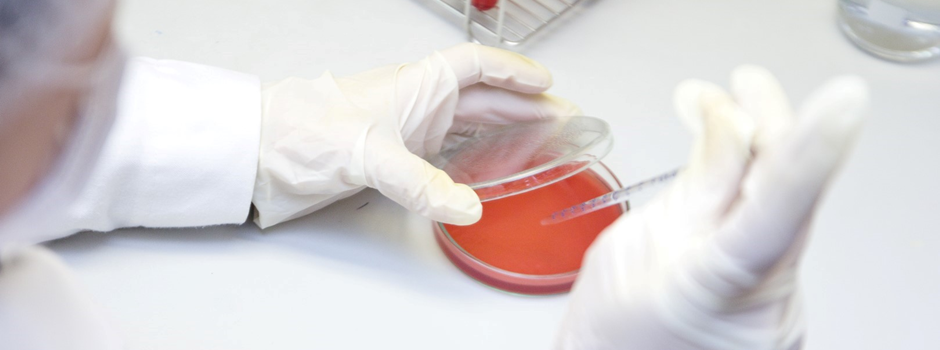

Microbiología Sanitaria
Realizamos Exámenes Microbiológicos de:
También brindamos asesoría a comedores y empresas de alimentos. El Examen Microbiológico Completo de Alimentos o Aguas Potables, Natural o de Sabor, incluyen las determinaciones que marca la norma NOM-093-SSA1-1994, así como las demás Normas Oficiales Mexicanas vigentes. De ordinario el tiempo de entrega de resultados de este tipo de estudios es de 5 días hábiles.
